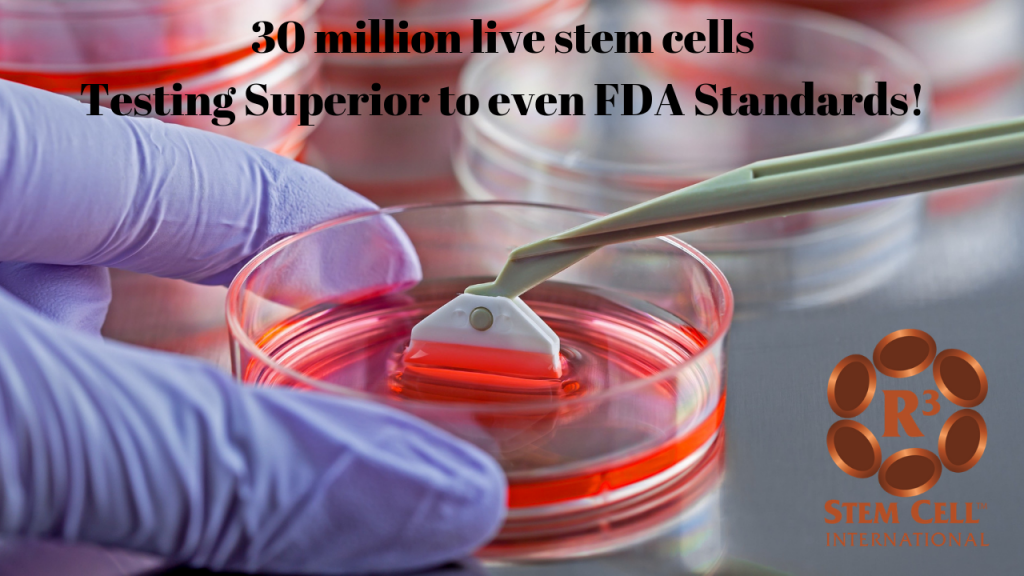

The Process for Individuals to Receive Stem Cell and Exosome Treatment with R3 International in Manila UAE
R3 International set up our clinic in Dubai to make regenerative procedures accessible in the Middle East with first rate biologics that have the highest safety standards globally. R3’s regenerative clinic is located in Dubai Healthcare City within 30 minutes of the airport.
Globally, R3’s Centers of Excellence have performed twenty seven thousand procedures in the past decade. We lead the world in regenerative education, safety, research, knowledge and outcomes. Our Centers serve the UAE with potent stem cell biologics that have exceptional viability and pass all USA FDA level safety standards.
“The staff took excellent care of us on every detail. Amazing people and excellent delivery of the whole experience. We felt great personal care in every aspect of our visit.” – John S
“The clinic and staff are very professional. I had a great time, from their pick up at the airport til everything was completed. The procedure at the clinic is quite simple. In a few hours, everything is finished. The doctor explained the injections to me (intravenous, in the hip, and in the back, at my request) and seems to be passionate about stem cells, it was a pleasure to chat with him 🙂
I can encourage you to go to this clinic.” – Julien B
“I just want to let you and the doctor know that my recovery has been nothing short of miraculous. I cannot believe this worked as well as it did. It’s like 20 years were taken off my knees!.” -Dan W
Here is the process for receiving stem cell and exosome therapy.
First, we need to know you’re interested. Either complete the Contact form HERE or call us at +97143838333
2. All prospective patients necessitate a virtual consultation with one of our experienced consultants. It only takes about 30 minutes to ensure you are a candidate and to answer your treatment questions. We’ll contact you to set it up, and there’s no obligation!
3. Once the virtual consultation is finished and if our consultant determines you to be a candidate for stem cell treatment, we will schedule the procedure at your desired timing.
5. Final payment is due prior to procedure being performed. Depending on your condition and its severity, you will receive anywhere from 50 million stem cells up to a few hundred million. The testing used by our lab is MORE stringent than what even the FDA requires in the States.
7. Your VIP Travel Representative will meet you at the Dubai airport and provide Escorted Transportation both to and from the hotel and clinic.
8. For patients receiving 100 million or more stem cells, R3 offers included lodging in a luxury hotel.
9. R3’s patient concierge representatives will follow up with you to see how you are doing!
R3 Offers Stem Cell Therapy by Injection, Intravenous, Nebulizer, Intrathecal, Epidural with USA Technology!